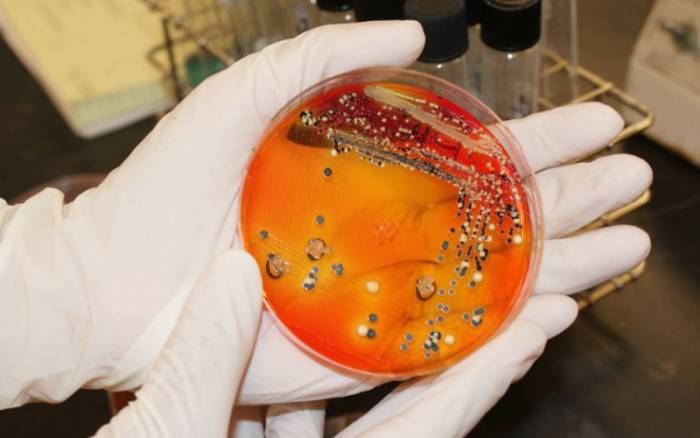
сальмонеллез

Сальмонеллез относится к болезням, способным быстро распространяться и наносить ущерб человеческому здоровью. Однако современная медицина нашла способы решения проблемы и лечения данного диагноза, даже на поздней стадии. Рассмотрим, что представляет собой недуг, как он проявляется, и когда можно ощутить первые признаки присутствия его возбудителей.
Что такое сальмонеллез
Сальмонеллез – инфекционная болезнь, локализующаяся в кишечнике человека. Она вызвана микроорганизмами – сальмонеллами, которые в народе признано называть кишечной палочкой. В зависимости от продолжительности инвазии, она может наносить здоровью лёгкие или тяжелые повреждения, в редких случаях отмечают летальный исход больного, спровоцированный не рациональной методикой лечения или отказом от терапии.
Заразиться сальмонеллезом можно от человека и от животных.
Заражение от человека происходит следующим образом:
Чтобы заразиться от больного, здоровый человек должен иметь слабый иммунитет и халатно относиться к личной гигиене, ведь чтобы проникнуть внутрь человека и начать развиваться, микроорганизмам нужно попасть в ротовую полость и пищевод. Следовательно, во избежание заражения требуется пересмотреть своё отношение к гигиеническим нормам и приучать детей к этому с рождения, ведь именно они чаще всего становятся источником массовых вспышек сальмонеллеза.

Заразиться от животных можно так:
Как правило, сальмонеллы не изменяют вкусовые качества продуктов, поэтому принимая заражённую пищу, человек не поймёт, что заразился, поэтому рекомендуется тщательно подойти к выбору пищевых продуктов и их обработке.
Также известны случаи, когда люди заражались кишечной палочкой через воду (в результате заглатывания водоёмной или морской воды), а также после приготовления бутербродов на разделочной доске. Именно поэтому специалисты рекомендуют иметь отдельную доску и ножи для мяса, которые требуется обрабатывать хлорным раствором после каждой разделки.
Врачи подчеркивают, что инкубационный период сальмонеллеза, как правило, составляет от 6 до 72 часов после заражения. Этот временной интервал может варьироваться в зависимости от индивидуальных особенностей организма и количества попавших в него бактерий. Симптомы заболевания, такие как диарея, рвота, лихорадка и abdominal pain, могут проявляться внезапно и приводить к значительному ухудшению состояния пациента. Врачи отмечают, что ранняя диагностика и своевременное лечение играют ключевую роль в предотвращении осложнений. Поэтому важно обращать внимание на возможные источники инфекции, такие как недостаточно термически обработанные продукты, и соблюдать правила гигиены. Профилактика остается важным аспектом в борьбе с сальмонеллезом, и врачи рекомендуют соблюдать осторожность при приготовлении и употреблении пищи.
https://youtube.com/watch?v=Y8UCRnVKppA
Инкубационный период сальмонеллеза

Как и любое другое заболевание, сальмонеллез имеет свой инкубационный период. Это означает, что у болезни существует определённый срок, когда бактерии начинают развиваться, но это не отражается на самочувствии больного.
У сальмонеллеза инкубационный период продолжительностью от 2 часов до 3 суток. У каждого человека он протекает по-разному и, это обусловлено качеством функциональности иммунной системы. Однако если возникает вспышка сальмонеллеза, то симптоматика болезни начинает появляться, не ранее чем через 7 суток со дня заражения.

Обычно люди не обращают внимания на болезнь, пока она не перейдёт на тяжелую стадию, характеризующуюся наличием агрессивных симптомов. Этим и опасно заражение сальмонеллезом. Первые признаки заражения кишечной палочкой таковы:
Также можно определить раннюю стадию сальмонеллеза по фекалиям. У зараженного человека кал становится пенистым и зелёным, это свидетельствует о том, что требуется срочно сдавать анализы и приступать к лечению. Данные меры требуется выполнять в обязательном порядке, несмотря на то, что дефекация проходит безболезненно.
Инкубационный период сальмонеллеза у детей

Малыши более агрессивно реагируют на заболевание. Обычно, инкубационный период сальмонеллеза у детей школьного и дошкольного возраста длиться 3-4 дня со дня заражения, а затем начинают проявляться первые признаки болезни:

При появлении таких симптомов, важно сразу же обратиться к врачу, ведь понос более 10 раз в сутки приводит к обезвоживанию организма и влияет на все его системы. Если ваш малыш заразился, требуется немедленно вызвать скорую помощь и собрать вещи, которые понадобятся для госпитализации. Сравнительно с другими инвазиями, диагноз – сальмонеллез лечат исключительно в стационарных условиях, ведь микроорганизмы нарушают функциональность внутренних органов и вызывают тяжелую интоксикацию.
Важно полностью пролечить зараженного сальмонеллезом и уничтожить абсолютно всех паразитов, ведь специалисты фиксируют много случаев, когда в результате неверной терапии человек выздоравливает, но в его фекалиях продолжают жить и размножаться микроорганизмы. На самочувствии самого человека это вовсе не отражается, но окружающие могут заразиться и пострадать от болезни.
Инкубационный период сальмонеллеза — это время, которое проходит от момента заражения до появления первых симптомов. Люди часто обсуждают, что он может варьироваться от 6 часов до 6 дней, в зависимости от штамма бактерии и индивидуальных особенностей организма. Многие отмечают, что симптомы, такие как диарея, рвота и боли в животе, могут возникать внезапно и быть довольно интенсивными. Это вызывает беспокойство, особенно у родителей маленьких детей и пожилых людей, которые более подвержены осложнениям. Важно помнить, что в этот период инфекция может передаваться другим, что делает соблюдение гигиенических норм особенно актуальным. Люди советуют быть внимательными к продуктам питания и соблюдать правила их хранения, чтобы избежать заражения.
https://youtube.com/watch?v=TN33o4LiRRU
Симптоматика сальмонеллеза

Когда инкубационный период уже прошёл, состояние человека может ухудшаться с разной скоростью, в зависимости от иммунитета. В данном случае важно не спутать сальмонеллез с отравлением, поэтому рекомендуется обращаться к врачу, а не заниматься самолечением!
У человека заражённого сальмонеллезом, может возникнуть несколько симптомов из списка ниже:
Кроме этого, проводя пальпацию можно нащупать увеличение печени и селезёнки. Однако увеличение размеров внутренних органов встречается не только при сальмонеллезе, но и других инвазиях, поэтому ощутив такие симптомы, следует немедленно обратиться к паразитологу и уточнить диагноз.
Диагностика сальмонеллеза

Диагностику сальмонеллеза выполняют исключительно путём сдачи анализов. Обычно на обследовании у врача, назначают такие исследования:
При незначительных проявлениях сальмонеллеза, взрослому человеку можно отказаться от стационара и лечиться в домашних условиях, но настоятельно не рекомендуется прибегать к этому, ведь пребывание зараженного вместе со здоровыми людьми опасно для окружающих.
Лечение

Терапия против сальмонеллеза назначается исключительно врачом и имеет комплексный характер.
Больному потребуется употреблять такие лекарственные препараты:

Кроме того, больному потребуется отдых и постельный режим. Питание зараженного заключается в употреблении витаминов и клетчатки, содержащейся в кашах. Разрешается есть запеченные яблоки, но категорически запрещено пить алкогольные напитки или принимать лекарства на спирту, есть копчёности, жареное, жирное, солёное.
Следовательно, сальмонеллез относится к заболеваниям, поражающим целые семьи и именно поэтому членам семьи зараженного следует провести капитальную уборку жилища с использованием хлорного раствора. Во избежание повторной инвазии, потребуется обратить внимание на правила приготовления пищи и личную гигиену, ведь паразиты могут проникнуть внутрь организма исключительно пероральным путём.
https://youtube.com/watch?v=woMXzC3w-KM
Вопрос-ответ
Какой Инкубационный период у сальмонеллеза?
Инкубационный период длится от 6 часов до 8 дней.
Как выглядит стул при сальмонеллезе?
Стул жидкий, водянистый, пенистый, зловонный, зеленоватого цвета от 5 до 10 раз в сутки. Через несколько дней после начала болезни в стуле появляется примесь слизи, изредка даже крови. Как правило, болезнь длится от 2 до 10 суток.
Советы
СОВЕТ №1
Следите за сроками годности продуктов. Сальмонелла часто встречается в сырых или плохо обработанных яйцах и мясе. Убедитесь, что вы используете свежие продукты и храните их в правильных условиях.
СОВЕТ №2
Соблюдайте правила гигиены на кухне. Регулярно мойте руки, кухонные принадлежности и поверхности, чтобы предотвратить перекрестное загрязнение. Это особенно важно после работы с сырыми продуктами.
СОВЕТ №3
Тщательно готовьте пищу. Убедитесь, что мясо и яйца готовятся до безопасной температуры, чтобы убить возможные бактерии. Используйте термометр для проверки готовности.
СОВЕТ №4
Обратите внимание на симптомы. Если вы подозреваете, что могли заразиться сальмонеллезом, такие как диарея, лихорадка или боли в животе, обратитесь к врачу для получения своевременной помощи.

